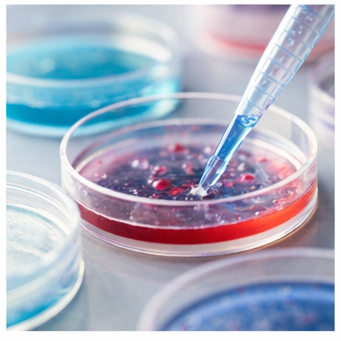

바이오관련대장주는 제약·바이오 산업 내에서 시가총액, 기술력, 시장 영향력 면에서 중심 역할을 하는 대표 기업을 의미합니다. 일반적으로 신약 개발 파이프라인을 보유하고 있거나 글로벌 임상 단계에 진입한 기업이 해당 범주에 포함됩니다.
바이오 산업은 신약 개발, 백신, 항체 치료제, 세포·유전자 치료제, 위탁생산(CMO) 등 다양한 세부 분야로 구성됩니다. 특히 최근에는 면역항암제, mRNA 백신, 세포치료제 분야가 빠르게 성장하고 있습니다.
! 핵심 포인트: 바이오주는 실적보다 “임상 결과·허가 여부”에 따라 주가 변동성이 매우 큽니다.
! 투자 전 확인: 임상 단계(1상·2상·3상)와 기술이전 계약 여부를 반드시 확인하세요.
국내 제약·바이오 기업 정보는 금융감독원 전자공시시스템 DART에서 확인할 수 있습니다.
https://dart.fss.or.kr
공시 자료를 통해 파이프라인 현황, 매출 구조, 연구개발비 비중 등을 분석하시면 보다 체계적인 접근이 가능합니다.



대표 바이오관련대장주 기업 분석
국내 바이오관련대장주로 자주 언급되는 기업은 다음과 같습니다.
- 삼성바이오로직스: 글로벌 위탁생산(CMO) 분야 세계 상위권 기업으로, 대형 제약사와 장기 계약을 체결하며 안정적 매출 구조를 확보하고 있습니다.
- 셀트리온: 바이오시밀러 대표 기업으로 유럽·미국 시장에서 경쟁력을 보이고 있습니다.
- SK바이오사이언스: 백신 개발 및 생산에 특화된 기업으로 글로벌 협력 프로젝트 경험을 보유하고 있습니다.
- 유한양행: 전통 제약사이면서도 신약 파이프라인 확대에 적극적인 기업입니다.
! 체크사항: 단순 시가총액이 아닌 “글로벌 매출 비중”과 “해외 임상 진행 여부”를 함께 보셔야 합니다.
기업별 IR 자료는 한국거래소(KRX) 홈페이지에서도 확인 가능합니다.
https://www.krx.co.kr



바이오관련대장주 투자 시 반드시 확인해야 할 지표
바이오관련대장주 투자를 고려하실 때는 재무제표만으로는 충분하지 않습니다.
첫째, 임상 단계 진행 상황을 확인해야 합니다. 3상 진입 여부는 상업화 가능성과 직결됩니다.
둘째, 기술수출 계약 규모를 확인해야 합니다. 기술이전 계약은 미래 매출의 선반영 요소로 작용합니다.
셋째, R&D 비율을 분석해야 합니다. 연구개발비 비중이 높을수록 성장성은 있지만 단기 수익성은 낮을 수 있습니다.
! 필수 확인 절차:
- DART 접속 → 기업명 검색
- 사업보고서 → 연구개발 현황 확인
- 최근 공시 → 기술이전 계약 유무 확인
또한 한국바이오협회 공식 사이트에서도 산업 동향을 확인할 수 있습니다.
https://www.koreabio.org
글로벌 바이오 시장 트렌드와 국내 영향
글로벌 바이오 시장은 고령화, 정밀의료, 유전자 치료 기술 발전에 힘입어 빠르게 확대되고 있습니다. 특히 미국 FDA 승인 여부는 국내 기업 주가에도 직접적인 영향을 줍니다.
미국 식품의약국(FDA) 승인 정보는 공식 사이트에서 확인 가능합니다.
https://www.fda.gov
! 중요 이슈: FDA 승인 발표일 전후로 변동성이 확대되는 경향이 있습니다.
! 대응 전략: 발표 일정 캘린더를 미리 체크하고 분할 매수 전략을 고려하세요.
최근에는 CDMO(위탁개발생산) 산업이 성장하면서 생산 기반 기업이 안정적인 투자 대안으로 평가받고 있습니다.

바이오관련대장주 FAQ – 투자자가 자주 묻는 질문
Q1. 바이오관련대장주는 언제 매수하는 것이 좋나요?
임상 결과 발표 직전은 기대감이 반영되지만 변동성이 큽니다. 발표 이후 방향성이 확정된 시점이 상대적으로 안정적입니다.
Q2. 적자 기업도 투자 대상이 될 수 있나요?
가능합니다. 다만 파이프라인 가치와 기술이전 계약 여부를 반드시 검토하셔야 합니다.
Q3. 장기 투자에 적합한가요?
CDMO 중심 기업은 장기 안정성, 신약 개발 기업은 고위험·고수익 구조로 구분하시는 것이 좋습니다.
! 핵심 요약: “임상 단계 + 기술수출 + 글로벌 승인 여부”가 가장 중요한 3대 요소입니다.
바이오관련대장주 투자 전략 정리
바이오관련대장주는 성장 산업의 중심에 위치한 만큼 장기적 기회가 존재합니다. 다만 높은 변동성을 동반하기 때문에 분산 투자와 정보 확인이 필수입니다.
- 대장주 + 중소형 유망주 분산 전략
- 공시 확인 후 투자
- 단기 급등 시 일부 차익 실현
바이오 산업은 정책, 규제, 기술 변화에 민감합니다. 따라서 산업 동향과 글로벌 승인 일정까지 함께 고려하는 체계적인 접근이 필요합니다.
페미니스트란?개념부터 역사, 오해와 진실까지 한눈에 정리
페미니스트란 무엇인지 궁금해하시는 분들이 많습니다. 최근 사회적 이슈와 함께 자주 언급되면서도 정확한 의미를 모르는 경우가 많기 때문입니다. 이 글에서는 페미니스트의 정의, 역사적 배
dooyo.kimsinfo.info
한글 문서 pdf변환 – 가장 쉬운 방법과 무료 사이트 추천
한글문서 PDF 변환은 업무, 과제 제출, 계약서 공유 등 다양한 상황에서 필수적으로 사용되는 작업입니다. 특히 HWP 파일은 한글 프로그램이 설치되지 않은 환경에서는 열리지 않는 경우가 많기
dooyo.kimsinfo.info
'생활' 카테고리의 다른 글
| 엑셀 텍스트 숫자 변환 – 오류 없이 한 번에 해결하는 방법 (0) | 2026.02.13 |
|---|---|
| 농협 주식계좌 개설방법– NH투자증권으로 쉽게 시작하는 투자 첫걸음 (0) | 2026.02.12 |
| 페미니스트란?개념부터 역사, 오해와 진실까지 한눈에 정리 (0) | 2026.02.12 |
| 65인치 tv가로세로사이즈 정리 – 설치 전 반드시 확인해야 할 실제 크기 가이드 (0) | 2026.02.11 |
| 엑셀 파일을 한글파일로 변환 – 초보자도 따라하는 설정 가이드 (0) | 2026.02.11 |